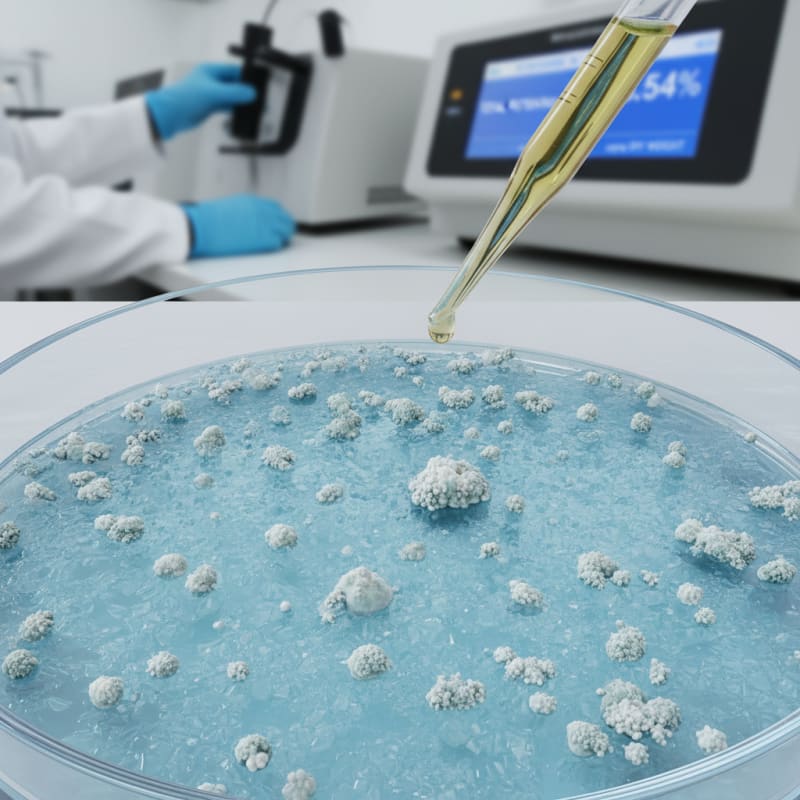
total potential psilocin meaning illustration 3

Total Potential Psilocin: What That Lab Report Number Really Means
Quick Summary
Total potential psilocin refers to the theoretical psychoactive content after psilocybin converts into psilocin in the body. It combines measured psilocybin and psilocin values to estimate overall active compound exposure.

Lab reports often list two numbers:
Psilocybin
Psilocin
Some reports include a third figure: Total Potential Psilocin. Understanding the total potential psilocin meaning requires chemistry.
What Is the Difference Between Psilocybin and Psilocin?
Psilocybin converts into psilocin after ingestion through dephosphorylation. Psilocin is the compound that binds to serotonin receptors and produces psychoactive effects.
Psilocybin acts as a stable precursor.
Why Do Labs Calculate Total Potential Psilocin?
Because psilocybin converts to psilocin in the body, labs sometimes express potency as a combined theoretical value. This is the total potential psilocin meaning on a Certificate of Analysis.
The formula adjusts for molecular weight difference between psilocybin and psilocin.
Simplified:
Total Potential Psilocin ≈ Measured Psilocin + (Measured Psilocybin × conversion factor)
The conversion factor accounts for molecular mass differences. This gives a clearer estimate of effective psychoactive potential.
Why Does This Matter for Potency Comparisons?
If a report shows:
- Psilocybin: 10 mg/g
- Psilocin: 1 mg/g
Total potential psilocin will exceed 11 mg/g due to the conversion adjustment.
Without understanding this, potency comparisons become misleading. Two products with identical psilocybin content but different psilocin levels will show different total potential psilocin values.
What Are the Limitations of This Calculation?
- It remains a theoretical calculation
- It assumes full metabolic conversion
- Individual metabolism varies
- Absorption rates differ between formats like capsules and chocolates
Lab numbers estimate exposure. They do not predict subjective intensity precisely.
What Are Detection Limits?
Lab reports also list:
- Limit of detection — the smallest amount the instrument can distinguish from zero
- Limit of quantitation — the smallest amount that can be measured with acceptable accuracy
"Not detected" does not mean zero. It means below instrument threshold.
Measurement precision defines interpretability.
Total potential psilocin clarifies potency.
Context clarifies expectation.
ShroomDash Editorial Team
Published 2026-02-20 · 5 min read · Lab Science



